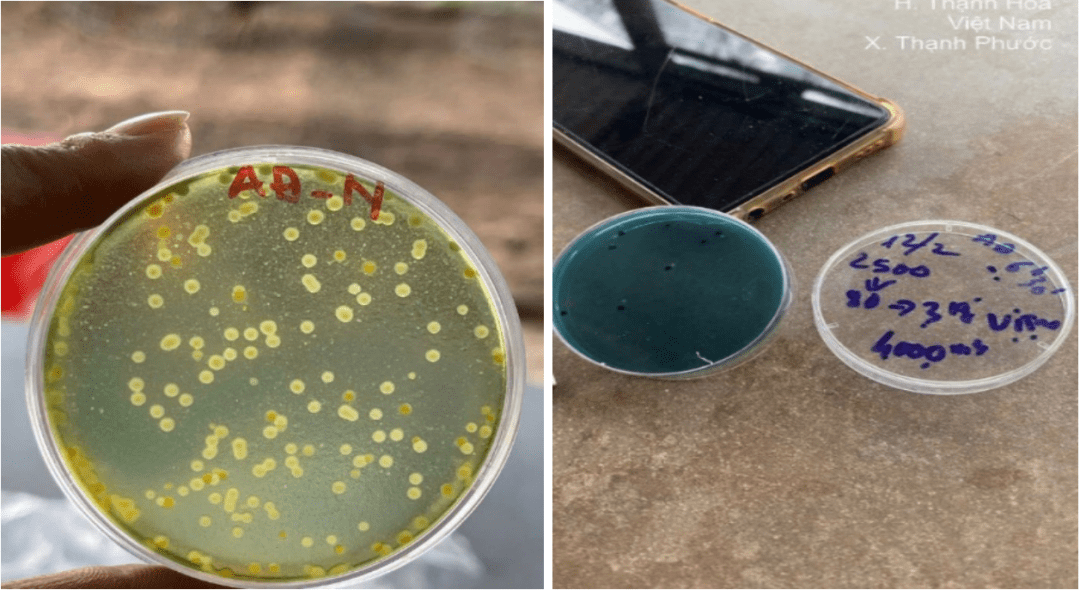

Tin mới nhất
[Người Nuôi Tôm] - Bệnh đường ruột ở tôm khá phổ biến với các biểu ...
Sinh ra từ vùng đất nhiều nắng gió Phú Yên cũ (nay là tỉnh Đắk ...
[Người Nuôi Tôm] - Amoniac (NH3) trong ao nuôi là yếu tố then chốt cần ...
1. Bệnh do Vibrio
Bệnh do Vibrio spp. là một trong những thách thức lớn trong ...
[Người Nuôi Tôm] - Ngày 15 - 16/9/2025, tại Hà Nội, nhận lời mời từ ...
[Người Nuôi Tôm] - Sau hơn 10 năm buộc phải san sẻ một phần diện ...
[Người Nuôi Tôm] - Nuôi tôm ở miền Bắc vốn được coi là "cuộc chơi ...
Nhờ ứng dụng công nghệ cao trong nuôi tôm, nhiều hộ dân xã Hoằng Châu ...
VASEP nhận định, trong cơ cấu sản phẩm xuất khẩi, tôm chân trắng vẫn giữ ...
[Người Nuôi Tôm] - Trong bối cảnh ngành nuôi tôm đang phải đối mặt với ...
Nuôi tôm công nghệ cao đang là giải pháp hiệu quả để hiện thực hóa ...
Dù xuất khẩu tôm của Ecuador đang tăng mạnh, đặc biệt đến các trung tâm ...
Hiện nay, bà con nông dân vùng sản xuất lúa – tôm ở Cà Mau ...
Trong bối cảnh ngành nuôi tôm đang hướng tới việc giảm thiểu sử dụng kháng ...
Liên tiếp hứng chịu ảnh hưởng nặng nề từ những cơn bão lớn, các hộ ...
Kính mời Quý độc giả đón đọc nội dung Người Nuôi Tôm số tháng 9/2025, ...
Sáng 11/9, Phó Chủ tịch UBND tỉnh Lê Văn Sử chủ trì hội nghị ký ...
Nông dân nuôi tôm càng xanh vùng Miệt Thứ (An Giang) năm nay trúng đậm ...
Hiện nay, ngư dân nuôi tôm biển ở tỉnh Đồng Tháp rất phấn khởi ...
Tin mới nhất
T3,28/10/2025
- Nông dân Thanh Hóa thành công với mô hình tôm công nghệ cao
- Nghệ An: Người nuôi tôm khẩn trương khắc phục thiệt hại bão số 10
- Mô hình nuôi tôm thẻ chân trắng nước ngọt tại Hưng Yên: Thành công bước đầu mở ra cơ hội mới
- Trường Đại học Cần Thơ tập huấn nâng cao kỹ năng cho người nuôi tôm
- Sáng kiến phát triển xét nghiệm nhanh WSSV trên tôm
- Thanh Hóa yêu cầu xử lý dứt điểm tình trạng nuôi tôm trái phép
- Sao Ta: Tốn gần 200 tỷ đồng thuế đối ứng
- Vitamin C: Tác động tới đặc điểm sinh sản và sinh lý ở tôm thẻ chân trắng bố mẹ
- Thanh Hóa: Khôi phục vùng nuôi thủy sản sau bão
- Pakistan: “Điểm nóng” mới của ngành tôm thế giới
Các ấn phẩm đã xuất bản
- Gần 500 hộ nuôi khẳng định hiệu quả Advance Pro – Tiến bộ kỹ thuật của Grobest
- Người nuôi tôm phập phồng với “ngày nắng, đêm mưa”
- Động lực phát triển đột phá ngành thủy sản
- Công nghệ sinh học toàn diện: Giải pháp nuôi tôm thành công từ Tâm Việt
- Biện pháp kiểm soát khí độc Nitrite (NO2) trong mô hình nuôi tôm TLSS-547
- Ngành chức năng và nông dân Quảng Nam cùng gỡ khó cho nuôi tôm nước lợ
- Thời tiết bất lợi gây thiệt hại hơn 27 triệu con tôm sú, tôm thẻ nuôi
- [Tuyển dụng] – Công ty TNHH Seven Hills Trading tuyển dụng nhiều vị trí hấp dẫn trong năm 2025
- Nhiều diện tích tôm nuôi của Nghệ An bị bệnh đốm trắng
- Nuôi tôm càng xanh VietGAP: Giảm chi phí, tăng lợi nhuận
- An toàn sinh học: Giải pháp then chốt cho bài toán dịch bệnh thủy sản
- Sử dụng sóng siêu âm để tính sinh khối ao nuôi tôm
- Máy sưởi ngâm: Cách mạng hóa nghề nuôi tôm ở Việt Nam
- Waterco: Giải pháp thiết bị hàng đầu trong nuôi trồng thủy sản
- GROSHIELD: “Trợ thủ đắc lực” giúp tôm đề kháng vững vàng hàng ngày, sẵn sàng về đích
- Năm mới, nỗi lo cũ: “Làm sao để tăng cường đề kháng cho tôm?”
- Vi sinh: Giải pháp mục tiêu toàn diện
- Grobest Việt Nam: Tiên phong ra mắt sản phẩm thức ăn chức năng hàng ngày Groshield, nâng cao tối đa sức đề kháng, hướng đến những vụ tôm về đích thành công trong năm tới
- Solagron Vietnam: Nhà sản xuất vi tảo công nghiệp đầu tiên mang dấu ấn Việt Nam
- Giải pháp giảm phát thải trong nuôi trồng thủy sản từ bột cá thủy phân